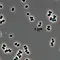

Galaxy S22 za i realme 11 Pro w doskonałych cenach. Play uruchomił świetną promocję
Play odpalił wakacyjną promocję, dzięki której można kupić ex-sztandarowy smartfon Samsunga w kapitalnej cenie. U konkurencji na próżno szukać Galaxy S22 5G za 2000 zł, tak samo, jak realme 11 Pro za 900 zł.

Rozpoczął się okres wakacji, a operatorzy sieci komórkowych zalewają nas promocjami. Orange odpalił ofertę, dzięki której możemy zyskać 600 GB na miesiąc, T-Mobile oferuje nielimitowany dostęp do internetu i rozmów za 50 zł, a Plus i Plush kusi darmowymi 400 GB internetu na start dla nowych klientów na kartę. Play dołącza się do imprezy i może nie rozdaje tony GB internetu, ale za to pozwala kupić smartfony w kapitalnych cenach.
Oto sposób na tanie smartfony. Galaxy S22 za 2000 zł i nowy realme 11 Pro za 9 stówek
Play dziś uruchomił promocję, w której zyskają osoby, które przeniosą numer do fioletowego operatora. Mogą zyskać dwa ciekawe smartfony 50 proc. taniej, co w obu przypadkach wydaje się świetną opcją. Aby skorzystać z takiej możliwości, trzeba przenieść numer od innego operatora i wybrać abonament w pakiecie Play M, L lub Homebox.
To otwiera furtkę do wzięcia Samsunga Galaxy S22 5G w cenie 1999 zł - smartfon w sklepach z elektroniką kosztuje 2,5-2,6 tys. zł, a więc mamy oszczędność na poziomie kilkuset złotych. W cenie średniaka to wręcz kapitalna propozycja. Mówimy przecież o byłym sztandarowcu Samsunga, który otrzyma jeszcze 3 duże aktualizacje Androida.

Drugim z łakomych kąsków jest nowiutki Realme 11 Pro, który zadebiutował w Polsce niespełna 2 tygodnie temu w cenie 1799 zł. Jednak przenosząc numer do Play, sprzęt można zakupić za 900 zł. Ponadto, jeśli zdecydujemy się na zakup do 4 lipca, możemy zgarnąć 200 zł zwrotu na konto, czyli finalnie zapłacimy za urządzenie 7 stówek. A to wręcz genialna cena jak za taki smartfon.
Jedyne, co musimy zrobić, to przejść do Play na abonament w pakiecie M, który kosztuje 65 zł na miesiąc, albo pakiet L, za który należy już zapłacić 85 zł miesięcznie. Za smartfony można zapłacić „jednorazowo” w jednej racie lub nawet 36 spłatach 0%.